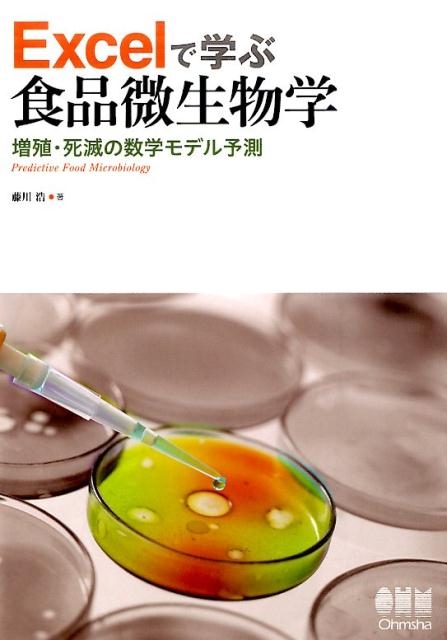

特集
構成数 : 1
| フォーマット | 書籍 |
| 発売日 | 2015年12月 |
| 国内/輸入 | 国内 |
| 出版社 | オーム社 |
| 構成数 | 1 |
| パッケージ仕様 | - |
| SKU | 9784274218217 |
| ページ数 | 181P |
| 判型 | A5 |

※ショッピングカートおよび注文内容の確認画面にてフラゲのお届けになるかご確認ください。
※各種前払い決済をご利用の場合、フラゲは保証しておりません。
※フラゲは配送日時指定なしでご注文いただいた場合に限ります。
読み込み中にエラーが発生しました。
画面をリロードして、再読み込みしてください。